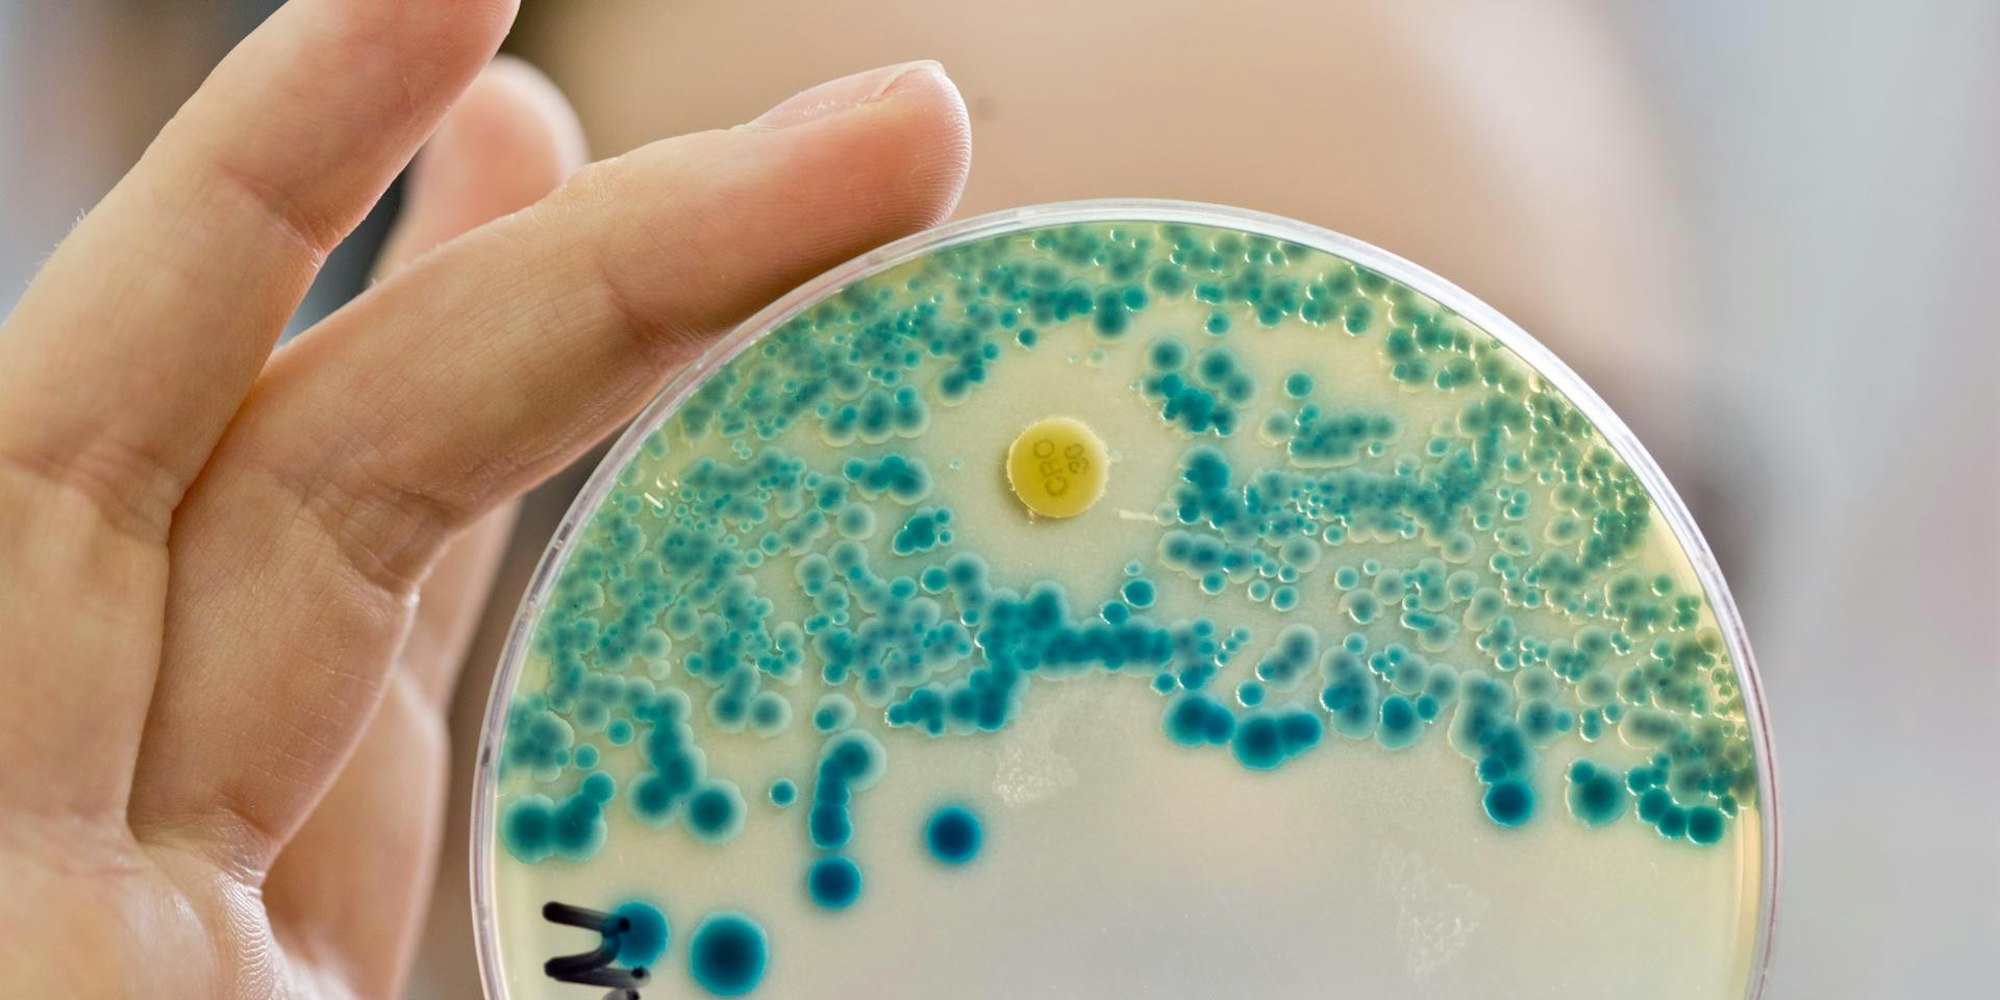

Nach TodesfallWas sind „fleischfressende Bakterien” und was richten sie im Körper an?
Nekrotisierende Fasziitis kann durch verschiedene Bakterien ausgelöst werden – häufigste Auslöser sind A-Streptokokken (Symbolbild).
Copyright: Daniel Karmann/dpa
Köln – Ein 66-Jähriger Mann stirbt 48 Stunden nachdem er im Meer gebadet hat. William Bennett hat sich beim Urlaub in Florida mit nekrotisierender Fasziitis („fleischfressende Bakterien“) infiziert. Seine Tochter Cheryl Bennett Wiygul schildert den Fall auf Facebook. Wie diese Krankheit entsteht und was Ärzte tun, um sie zu behandeln sowie die wichtigsten Fakten haben wir zusammengefasst.
Das Schicksal ihres Vaters hat Cheryl Bennett laut ihrem Facebook-Post öffentlich gemacht, um andere Menschen vor nekrotisierender Fasziitis zu warnen. Zum Fall ihres Vaters: Ihre Eltern hatten sie in Florida besucht und Urlaub gemacht. Ihr Vater litt unter einer langjährigen Krebserkrankung und hatte deswegen ein geschwächtes Immunsystem.
Eltern wollten zu ihren eigenen Ärzten gehen
Wenige Stunden nach dem Bad im Meer litt Bennett laut seiner Tochter unter Fieber, Schüttelfrost und Schmerzen. Die Eltern gingen nicht direkt in Florida zu einem Arzt, denn sie hatten ihre Rückreise für den nächsten Tag angesetzt – sie wollten stattdessen lieber zu den Ärzten in Memphis gehen, die die Krankengeschichte des Mannes kannten.
In Memphis aber diagnostizieren die Ärzte die Infektionskrankheit bei ihrem Vater laut der Tochter nicht direkt, auch nicht nach Hinweisen der Mutter. Cheryl Bennett Wiygul schreibt in ihrem Post, dass sie wegen einem Todesfall in Florida wenige Wochen zuvor, gehört hätte, dass man sich im Meer durch offene Wunden mit den Bakterien infizieren könnten.
Was ist nekrotisierende Fasziitis?
Nekrotisierende Fasziitis ist eine seltene Infektion, die durch Bakterien ausgelöst wird. Es gibt verschiedene Arten von Bakterien, die die Krankheit auslösen können – der häufigste Auslöser sind A-Streptokokken. Meist leben sie auf der Haut oder im Rachen von Menschen, ohne Schäden anzurichten. In manchen Fällen können sie Scharlach auslösen oder eben eine nekrotisierende Fasziitis.
Die Entzündung befällt das Bindegewebe und Faszien und sorgt dafür, dass sie absterben. Es handelt sich um eine Infektion, die sich schnell im Körper ausbreitet – sie kann innerhalb von Stunden oder Tagen lebensbedrohlich werden. Wird die Krankheit nicht erkannt und nicht behandelt, sterben bis zu Drei Viertel der Betroffenen. In der Regel kann das Immunsystem eindringende Bakterien abtöten, deshalb sind es oft ältere Menschen mit einem geschwächten Immunsystem, die erkranken, aber auch junge, gesunde Menschen können die Krankheit bekommen.
Wie gelangen die Bakterien in den Körper?
„Oft gibt es Eintrittspunkte – ein Schnitt, der durch die Haut in tiefere Bereiche vordringt, manchmal auch ein Stich wie von einem Dorn oder einer Nadel. Es könnte auch ein Insektenstich sein“, sagt der Spezialist für Infektionskrankheiten der Vanderbilt Universität William Schaffner gegenüber dem National Geographic. Oft können Ärzte aber nicht feststellen, woher das Bakterium stammt.
Wie sehen die ersten Symptome aus?
An den betroffenen Stellen bekommen die Betroffene schlimme Schmerzen. Dazu kommen meist noch Fieber, Schüttelfrost und auch Übelkeit und Erbrechen.
Das könnte Sie auch interessieren:
Welche Behandlungsmöglichkeiten gibt es?
„Die zwei wesentlichen Therapieansätze sind Antibiotika, um die Infektion zu bekämpfen, und eine OP, um Sauerstoff zuzuführen“, sagt Schaffner. Viele der beteiligten Bakterien seien anaerob, was bedeutet, dass sie in sauerstoffarmen Umgebungen gedeihen.
Wenn sie mit Luft in Berührung kommen, sterben sie. Die Chirurgen müssten außerdem totes und beschädigtes Gewebe entfernen, damit die Wunden besser heilen, erklärt Schaffner gegenüber der National Geographic. (dmn)